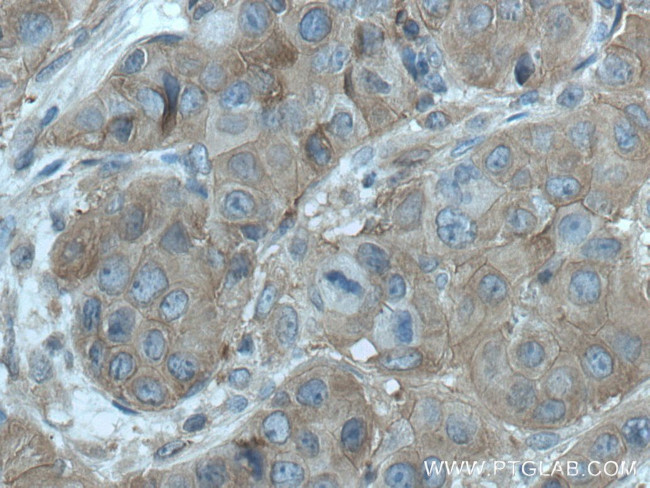
PLSCR3 Antibody in Immunohistochemistry (Paraffin) (IHC (P))

Search
Proteintech
PLSCR3 Polyclonal Antibody
{{$productOrderCtrl.translations['antibody.pdp.commerceCard.promotion.promotions']}}
{{$productOrderCtrl.translations['antibody.pdp.commerceCard.promotion.viewpromo']}}
{{$productOrderCtrl.translations['antibody.pdp.commerceCard.promotion.promocode']}}: {{promo.promoCode}} {{promo.promoTitle}} {{promo.promoDescription}}. {{$productOrderCtrl.translations['antibody.pdp.commerceCard.promotion.learnmore']}}
产品信息
28028-1-AP
种属反应
宿主/亚型
分类
类型
抗原
偶联物
形式
浓度
规格
纯化类型
保存液
内含物
保存条件
运输条件
产品详细信息
Immunogen sequence: MAGYLPPKG YAPSPPPPYP VTPGYPEPAL HPGPGQAPVP AQVPAPAPGF ALFPSPGPVA LGSAAPFLPL PGVPSGLEFL VQIDQILIHQ KAERVETFLG WETCNRYELR SGAGQPLGQA AEESNCCARL CCGARRPLRV RLADPGDREL LRLLRPLHCG CSCCPCGLQE MEVQAPPGTT IGHVLQTWHP FLPKFSIQDA DRQTVLRVVG PCWTCGCGTD TNFEVKTRDE SRSVGRISKQ WGGLVREALT DADDFGLQFP LDLDVRVKAV LLGATFLIDY MFFEKRGGAG PSAITS (1-295 aa encoded by B C011735)
靶标信息
May mediate accelerated ATP-independent bidirectional transbilayer migration of phospholipids upon binding calcium ions that results in a loss of phospholipid asymmetry in the plasma membrane. May play a central role in the initiation of fibrin clot formation, in the activation of mast cells and in the recognition of apoptotic and injured cells by the reticuloendothelial system. Seems to play a role in apoptosis, through translocation of cardiolipin from the inner to the outer mitochondrial membrane which promotes BID recruitment and enhances tBid-induced mitochondrial damages. [UniProt]
仅用于科研。不用于诊断过程。未经明确授权不得转售。
生物信息学
蛋白别名: Ca 2+ dependent phospholipid scramblase 3; Ca(2+)-dependent phospholipid scramblase 3; Phospholipid scramblase 3; PL scramblase 3; unnamed protein product
基因别名: 2210403O21Rik; 2610037N06Rik; ESTM3; PLSCR3; X83310
UniProt ID: (Human) Q9NRY6, (Mouse) Q9JIZ9
Entrez Gene ID: (Human) 57048, (Mouse) 70310